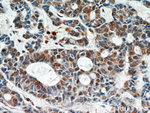
STAT4 Antibody in Immunohistochemistry (Paraffin) (IHC (P))
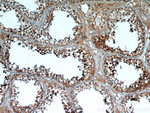
STAT4 Antibody in Immunohistochemistry (Paraffin) (IHC (P))

Search
Proteintech
STAT4 Polyclonal Antibody
{{$productOrderCtrl.translations['antibody.pdp.commerceCard.promotion.promotions']}}
{{$productOrderCtrl.translations['antibody.pdp.commerceCard.promotion.viewpromo']}}
{{$productOrderCtrl.translations['antibody.pdp.commerceCard.promotion.promocode']}}: {{promo.promoCode}} {{promo.promoTitle}} {{promo.promoDescription}}. {{$productOrderCtrl.translations['antibody.pdp.commerceCard.promotion.learnmore']}}
产品信息
51070-2-AP
宿主/亚型
分类
类型
抗原
偶联物
形式
浓度
规格
保存条件
运输条件
靶标信息
STAT4 was originally identified using degenerate primers complementary to sequences encoding conserved regions of other STAT proteins. The STAT4 protein is most similar to STAT1 (52%) and STAT3 (47%). Functionally, STAT4 is similar to other STAT family members in that it can be tyrosine phosphorylated by Jak1 or Jak2. STAT4 forms homodimers and heterodimers with related STAT family members. Tyrosine phosphorylated STAT4 can bind the IFN-gamma activated site (GAS). Serine phosphorylation of STAT is also required for maximal transcriptional activity. STAT4 expression is restricted to the thymus, spleen and testis. Until recently the cytokine(s) responsible for activation of STAT4 had not been identified. STAT4 is now known to be activated by the cytokine interleukin 12 (IL-12). IL-12 is required for the T-cell independent induction of IFN-gamma which is a key step in the initial suppression of bacterial and parasitic infections. In addition, IL-12 is required for the development of a Th1 response which is necessary for effective host defense against intracellular pathogens. STAT4-deficient mice display impaired IL-12 development of Th1 cells and enhanced development of Th2 cells. A recent study in mouse has shown that in response to viral infection IFN-a/b activation of STAT4 is required for IFN-g production.
仅用于科研。不用于诊断过程。未经明确授权不得转售。